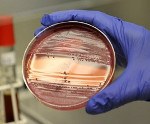

Другие названия и синонимы
Neurobrucellosis.
МКБ-10 коды
- МКБ-10
- A23 Бруцеллез
|
|
Описание
Нейробруцеллез. Патология нервной системы, возникающая на фоне бруцеллезной инфекции. Клиническая картина полиморфна, в зависимости от локализации патологического процесса представлена невритами, радикулитами, менингитом, энцефалитом, миелитом. Диагностируется нейробруцеллез на основании эпидемиологического анамнеза, неврологического осмотра, бактериологических, серологических исследований, анализа ликвора, нейровизуализации, ЭНМГ. Лечение включает антибиотикотерапию, симптоматические средства (мочегонные, стероидные, сосудистые, антихолинэстеразные, психотропные препараты), физиотерапию.

Дополнительные факты
Бруцеллез - зоонозное инфекционное заболевание, актуальное для животноводческих регионов. В 80% случаев острая форма инфекции принимает хроническое течение, обусловленное внутриклеточным персистированием бруцелл. Нейробруцеллез встречается у 3-5% больных бруцеллезом, чаще развивается на фоне хронической формы заболевания, иногда является первым клиническим проявлением. Поражаются преимущественно периферическая и вегетативная нервная система (НС). Нейробруцеллез распространён в местностях, где расположены животноводческие хозяйства. В России повышенная заболеваемость отмечается на Урале, Северном Кавказе, в Сибири. Риск заболевания повышен у работников животноводства, людей, связанных с обработкой шкур, разделкой туш. Пик заболеваемости приходится на наиболее трудоспособный возраст - 25-45 лет.
Причины
Патологический процесс в нервной системе является частью генерализованного инфекционного поражения организма бруцеллами. Последние представляют собой устойчивые в окружающей среде грамположительные бактерии. Резервуаром бруцелл выступают домашние животные: овцы, крупный рогатый скот, козы, свиньи. Проникновение возбудителей в организм человека происходит следующими путями:
• Алиментарным. Контаминированы бруцеллами могут быть вода, пищевые продукты. Особую опасность представляет молоко, кисломолочные продукты из непастеризованного сырья (брынза, кефир, сливки), термически плохо обработанное мясо. Попадание бруцелл в пищу возможно с загрязнённых рук, одежды.
• Контактным. При уходе за животными, обработке сырья бактерии могут проникать через микротрещены, ранки на коже. Попадая в кровь, они разносятся по организму. Контактный механизм заражения реализуется значительно реже алиментарного.
• Воздушно. Пылевым. Бруцеллы переносятся по воздуху пылинками, представляющими собой частички земли, шерсти, испражнений животных. Заражение человека происходит при вдыхании воздуха, содержащего обсеменённые бруцеллами пылевые частицы.
Проникшие в организм бруцеллы подвергаются атаке защитных иммунных агентов и могут быть уничтожены. Развитие инфекционного процесса происходит при инфицировании большим количеством бактерий, сниженном иммунитете, гиповитаминозе, ослабленном состоянии вследствие частых ОРВИ, хронических заболеваний, переутомлений.
• Алиментарным. Контаминированы бруцеллами могут быть вода, пищевые продукты. Особую опасность представляет молоко, кисломолочные продукты из непастеризованного сырья (брынза, кефир, сливки), термически плохо обработанное мясо. Попадание бруцелл в пищу возможно с загрязнённых рук, одежды.
• Контактным. При уходе за животными, обработке сырья бактерии могут проникать через микротрещены, ранки на коже. Попадая в кровь, они разносятся по организму. Контактный механизм заражения реализуется значительно реже алиментарного.
• Воздушно. Пылевым. Бруцеллы переносятся по воздуху пылинками, представляющими собой частички земли, шерсти, испражнений животных. Заражение человека происходит при вдыхании воздуха, содержащего обсеменённые бруцеллами пылевые частицы.
Проникшие в организм бруцеллы подвергаются атаке защитных иммунных агентов и могут быть уничтожены. Развитие инфекционного процесса происходит при инфицировании большим количеством бактерий, сниженном иммунитете, гиповитаминозе, ослабленном состоянии вследствие частых ОРВИ, хронических заболеваний, переутомлений.
Патогенез
Нейробруцеллез возникает вследствие гематогенного, лимфогенного заноса возбудителей в нервные ткани. Благодаря антилизоцимной активности бруцеллы способны длительно персистировать в нервных клетках. Периневральное распространение бактерий обуславливает постепенное прогрессирование поражения. Инфекционный процесс сопровождается сенсибилизацией, вызывающей срабатывание аутоиммунных механизмов. В остром периоде в поражённых нервных стволах, тканях ЦНС доминирует серозное инфекционно-аутоиммунное воспаление. Вовлечение в воспалительный процесс сосудов с развитием васкулита обуславливает геморрагический компонент - петехиальные кровоизлияния вследствие повышенной проницаемости сосудистой стенки. В хронической фазе преобладают дегенеративные изменения. Микроскопически отмечается патология цитоплазмы нейронов (вакуолизация, тигролиз), набухание и фрагментация нервных волокон.
Классификация
Нейробруцеллез не имеет общепринятой классификации. Отечественные специалисты в области неврологии предпочитают использовать клинико-топографическое разделение различных форм заболевания. Соответственно данному подходу выделяют 4 основных варианта нейробруцеллеза.
• Поражения периферической НС. Наиболее типичный вариант заболевания. Включает невриты, полиневропатии, плекситы, радикулиты. Первое место по частоте встречаемости занимают неврит седалищного нерва, пояснично-крестцовый плексит.
• Бруцеллезные поражения ЦНС. Возможны следующие клинические формы: менингит, энцефалит, менингоэнцефалит, миелит, энцефаломиелит. Нейробруцеллез ЦНС встречается в 1,6% случаев бруцеллезной инфекции.
• Сосудистые поражения ЦНС. Возникают в результате церебрального васкулита. К ним относятся субарахноидальные кровоизлияния, вазомоторные расстройства (ПНМК, ТИА), ишемические инсульты, паренхиматозные кровоизлияния.
• Поражения вегетативной НС. Наблюдаются у 90% больных. Возможен гипергидроз, сухость кожи, вегетативные боли, вегето-сосудистая дистония, нарушения секреторной и моторной функции ЖКТ.
• Поражения периферической НС. Наиболее типичный вариант заболевания. Включает невриты, полиневропатии, плекситы, радикулиты. Первое место по частоте встречаемости занимают неврит седалищного нерва, пояснично-крестцовый плексит.
• Бруцеллезные поражения ЦНС. Возможны следующие клинические формы: менингит, энцефалит, менингоэнцефалит, миелит, энцефаломиелит. Нейробруцеллез ЦНС встречается в 1,6% случаев бруцеллезной инфекции.
• Сосудистые поражения ЦНС. Возникают в результате церебрального васкулита. К ним относятся субарахноидальные кровоизлияния, вазомоторные расстройства (ПНМК, ТИА), ишемические инсульты, паренхиматозные кровоизлияния.
• Поражения вегетативной НС. Наблюдаются у 90% больных. Возможен гипергидроз, сухость кожи, вегетативные боли, вегето-сосудистая дистония, нарушения секреторной и моторной функции ЖКТ.
Клиническая картина
Инкубационный период длится 1-4 недели. Возможно продолжающееся несколько месяцев первично латентное течение инфекции, которое может сопровождаться вегетативными расстройствами. В остром септическом периоде нейробруцеллез возникает в форме менингита, сосудистых поражений. Бруцеллезный менингит проявляется менингеальным синдромом, появлением триггерных точек на голове, шее. В отдельных случаях менингит имеет скрытое течение, диагностируется только по анализу спинномозговой жидкости. Вазомоторные мозговые нарушения отличаются преходящим характером очаговой симптоматики (парезов, расстройств речи, зрительной функции). Субарахноидальное кровоизлияние протекает с интенсивной головной болью, оболочечной симптоматикой, дисфункцией черепно-мозговых нервов. Инсульты характеризуются типичной клинической картиной.
Нейробруцеллез с поражением периферических нервов дебютирует после уменьшения лихорадки в острой фазе инфекции или на стадии хронического течения. Отмечаются моно- и полиневриты, невралгии, плекситы, корешковые синдромы, чаще с воспалением седалищного нерва, сплетений и корешков поясничной локализации. Отличительной особенностью бруцеллезного поясничного плексита и радикулита является разлитой болевой синдром, охватывающий всю ягодичную область. Полиневриты бывают асимметричны, не обязательно распространяются на все конечности, сопровождаются вегетативной симптоматикой: похолодание, синюшность, потливость, отёчность дистальных отделов конечностей.
Нейробруцеллез может протекать с поражением черепных нервов. Наиболее часто воспаление затрагивает оптический и преддверно-улитковый нервы. В первом случае наблюдается снижение остроты зрения, ощущение «тумана перед глазами», во втором - снижение слуха. Тугоухость носит двусторонний характер, может выступать единственным симптомом нейробруцеллеза после перенесённого острого периода инфекции.
Бруцеллезное воспаление церебральных тканей (энцефалит) отличается полиморфной симптоматикой. Наблюдаются спастические парезы, проводниковые расстройства чувствительности, мозжечковый синдром, вестибулярная атаксия, нарушения речи. Реже возникают миоклонии, экстрапирамидные нарушения (хореические гиперкинезы, паркинсонизм), психические расстройства (психомоторное возбуждение, галлюцинаторный синдром, эйфорические состояния, бред).
Ассоциированные симптомы: Боль во всей голове. Галлюцинации. Потливость. Эйфория.
Нейробруцеллез с поражением периферических нервов дебютирует после уменьшения лихорадки в острой фазе инфекции или на стадии хронического течения. Отмечаются моно- и полиневриты, невралгии, плекситы, корешковые синдромы, чаще с воспалением седалищного нерва, сплетений и корешков поясничной локализации. Отличительной особенностью бруцеллезного поясничного плексита и радикулита является разлитой болевой синдром, охватывающий всю ягодичную область. Полиневриты бывают асимметричны, не обязательно распространяются на все конечности, сопровождаются вегетативной симптоматикой: похолодание, синюшность, потливость, отёчность дистальных отделов конечностей.
Нейробруцеллез может протекать с поражением черепных нервов. Наиболее часто воспаление затрагивает оптический и преддверно-улитковый нервы. В первом случае наблюдается снижение остроты зрения, ощущение «тумана перед глазами», во втором - снижение слуха. Тугоухость носит двусторонний характер, может выступать единственным симптомом нейробруцеллеза после перенесённого острого периода инфекции.
Бруцеллезное воспаление церебральных тканей (энцефалит) отличается полиморфной симптоматикой. Наблюдаются спастические парезы, проводниковые расстройства чувствительности, мозжечковый синдром, вестибулярная атаксия, нарушения речи. Реже возникают миоклонии, экстрапирамидные нарушения (хореические гиперкинезы, паркинсонизм), психические расстройства (психомоторное возбуждение, галлюцинаторный синдром, эйфорические состояния, бред).
Ассоциированные симптомы: Боль во всей голове. Галлюцинации. Потливость. Эйфория.
|
|
Возможные осложнения
В отсутствие своевременного лечения воспалительные изменения нервных стволов приводят к необратимому нарушению функции поражённого нерва: развитию пареза, стойких нарушений зрения, слуха. Наиболее тяжёлые остаточные явления (парезы, параличи, контрактуры суставов) сопровождают церебральный и спинальный нейробруцеллез. Грозным осложнением является отёк головного мозга, развивающийся вследствие диффузных воспалительных изменений церебральных тканей, внутричерепного кровоизлияния, обширного ишемического инсульта. Происходящее в результате выраженного отёка смещение мозговых структур опасно ущемлением продолговатого мозга с угнетением локализующихся в нём витальных центров.
Диагностика
Важным диагностическим моментом является сбор анамнестических данных: эпидемиологических (профессиональная деятельность, место проживания, контакт с животными), клинических (предшествующая волнообразная лихорадка, артралгии, миалгии, лимфоаденопатия, гепатоспленомегалия). Обследование пациента включает консультации смежных специалистов: инфекциониста, невролога, офтальмолога, ревматолога. В перечень диагностических исследований входят:
• Клинические анализы. Общий анализ крови и мочи, биохимический анализ крови. Для исключения ревматизма проводится определение уровня ревматоидного фактора, С-реактивного белка.
• Бактериологическая диагностика. С целью выявления инфекционного агента проводится бакпосев крови, спинномозговой жидкости, пунктата лимфоузла (при аденопатии), синовиальной жидкости (при артрите).
• Серологические исследования. Экспресс-диагностика проводится при помощи реакции агглютинации на стекле Хеддельсона. Более достоверна реакция агглютинации Райта. Оба анализа дают положительный результат у ранее переболевших людей, привитых от бруцеллеза пациентов.
• Проба Бюрне. Специфическая кожная аллергопроба с бруцеллином положительна к концу первого месяца болезни у 70-85% больных.
• Исследование цереброспинальной жидкости. Нейробруцеллез с поражением ЦНС сопровождается увеличением концентрации белка, лимфоцитарным плеоцитозом. Прозрачность ликвора свидетельствует о серозном характере воспаления, наличие крови - о субарахноидальном кровоизлиянии.
• Методы нейровизуализации. КТ, МРТ, МСКТ головного мозга выявляют диффузные неспецифические изменения белого вещества. Позволяют диагностировать инсульт, интракраниальные кровоизлияния, исключить очаговую патологию мозга (опухоль, кисту).
• Электромионейрография. Выявляет снижение проводящей способности поражённых нервов. Помогает установить характер и уровень поражения периферической НС.
• Клинические анализы. Общий анализ крови и мочи, биохимический анализ крови. Для исключения ревматизма проводится определение уровня ревматоидного фактора, С-реактивного белка.
• Бактериологическая диагностика. С целью выявления инфекционного агента проводится бакпосев крови, спинномозговой жидкости, пунктата лимфоузла (при аденопатии), синовиальной жидкости (при артрите).
• Серологические исследования. Экспресс-диагностика проводится при помощи реакции агглютинации на стекле Хеддельсона. Более достоверна реакция агглютинации Райта. Оба анализа дают положительный результат у ранее переболевших людей, привитых от бруцеллеза пациентов.
• Проба Бюрне. Специфическая кожная аллергопроба с бруцеллином положительна к концу первого месяца болезни у 70-85% больных.
• Исследование цереброспинальной жидкости. Нейробруцеллез с поражением ЦНС сопровождается увеличением концентрации белка, лимфоцитарным плеоцитозом. Прозрачность ликвора свидетельствует о серозном характере воспаления, наличие крови - о субарахноидальном кровоизлиянии.
• Методы нейровизуализации. КТ, МРТ, МСКТ головного мозга выявляют диффузные неспецифические изменения белого вещества. Позволяют диагностировать инсульт, интракраниальные кровоизлияния, исключить очаговую патологию мозга (опухоль, кисту).
• Электромионейрография. Выявляет снижение проводящей способности поражённых нервов. Помогает установить характер и уровень поражения периферической НС.
Дифференциальная диагностика
Дифференцировать нейробруцеллез следует с целым рядом заболеваний. Дифдиагностика осуществляется с нейроревматизмом, нейросифилисом, туляремией, энцефалитами, менингитами, миелитами вирусной этиологии. Бруцеллезные поражения нервов, спинальных корешков и сплетений необходимо отличать от вертеброгенных синдромов, опухолей нервов, дисметаболических осложнений (например, диабетической нейропатии).
Лечение
Терапия направлена на элиминацию возбудителя, предупреждение осложнений, восстановление утраченных нервных функций. Нейробруцеллез острой и подострой фазы требует стационарного лечения с долечиванием в амбулаторных условиях. Лечение проводится длительно (в течение нескольких месяцев), включает следующие составляющие:
• Антибактериальная терапия. Проводится комбинацией двух антибиотиков, широко применяется сочетание рифампицина с гентамицином, доксициклином. При менингите, энцефалите осуществляется парентеральное введение препаратов с последующим переходом на пероральный приём. Хроническая форма является показанием к введению противобруцеллезной вакцины.
• Симптоматическое лечение. Профилактика отёка мозга осуществляется диуретиками, осмодиуретиками. В тяжёлых случаях назначают глюкокортикостероиды. Восстановлению двигательной сферы способствуют антихолинэстеразные фармпрепараты (неостигмин). Сосудистые нарушения корректируются вазоактивными, антиагрегантными средствами; психические отклонения - психотропными препаратами.
• Физиотерапия. Эффективна в лечении патологии периферической НС. Применяются УВЧ, электрофорез, парафинотерапия, грязелечение. В реабилитационном периоде для восстановления объёма движений используется массаж, лечебная физкультура, рефлексотерапия.
• Антибактериальная терапия. Проводится комбинацией двух антибиотиков, широко применяется сочетание рифампицина с гентамицином, доксициклином. При менингите, энцефалите осуществляется парентеральное введение препаратов с последующим переходом на пероральный приём. Хроническая форма является показанием к введению противобруцеллезной вакцины.
• Симптоматическое лечение. Профилактика отёка мозга осуществляется диуретиками, осмодиуретиками. В тяжёлых случаях назначают глюкокортикостероиды. Восстановлению двигательной сферы способствуют антихолинэстеразные фармпрепараты (неостигмин). Сосудистые нарушения корректируются вазоактивными, антиагрегантными средствами; психические отклонения - психотропными препаратами.
• Физиотерапия. Эффективна в лечении патологии периферической НС. Применяются УВЧ, электрофорез, парафинотерапия, грязелечение. В реабилитационном периоде для восстановления объёма движений используется массаж, лечебная физкультура, рефлексотерапия.
Прогноз
Исход заболевания зависит от его формы. При энцефалитах, церебральной сосудистой патологии прогноз серьёзный. Своевременная этиотропная терапия способствует выздоровлению большей части пациентов. В ряде случаев у перенёсших нейробруцеллез наблюдаются стойкие резидуальные последствия: расстройства зрения, тугоухость, парез Персистирование бруцелл обуславливает возможность рецидивов.
Профилактика
Профилактические мероприятия идентичны профилактике бруцеллеза, включают: ветеринарный контроль, регулярные обследования животноводов, контроль пищевой продукции. Специфическая профилактика проводится бруцеллезной вакциной, которая вводится животным в плановом порядке. Людям вакцинация против бруцеллеза производится по эпидемическим показаниям.